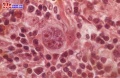
Bk92p.jpg

未使用文件
来自医学百科
下面为未被任何页面使用的文件。请注意,其他网站可能会通过URL直接链接某个文件,因此列表中的文件有可能仍在使用。
下面显示区间#2,451至#2,500的50条结果。
查看(前50个 | 后50个)(20 | 50 | 100 | 250 | 500)
- Bk56c.jpg 1,279 × 853;53 KB
- Bkkya.jpg 350 × 456;43 KB
- Ajqqno.gif 139 × 21;2 KB
- Bknfk.jpg 300 × 247;28 KB
- Gxpq0a7h.jpg 393 × 312;15 KB
- Bkipz.jpg 500 × 353;31 KB
- Bkain.jpg 397 × 567;169 KB
- Bk2cx.jpg 900 × 600;80 KB
- Gj5q37ma.jpg 327 × 203;20 KB
- Bk328.jpg 284 × 204;9 KB
- 3333333.png 320 × 237;30 KB
- Gkruh5eg.jpg 229 × 212;7 KB
- Bk25q.jpg 204 × 291;10 KB
- Guwf0raj.jpg 386 × 232;8 KB
- Bknfh.jpg 300 × 183;7 KB
- Bkm9m.jpg 140 × 103;4 KB
- Gq0ra62s.jpg 429 × 326;26 KB
- Gum5odb6.jpg 252 × 50;2 KB
- Bk1iu.jpg 480 × 327;99 KB
- Gv7sg11i.jpg 489 × 256;13 KB
- Guwgh5ns.jpg 167 × 192;3 KB
- Bk6tg.jpg 140 × 104;4 KB
- Bk2in.jpg 632 × 810;130 KB
- Bk2qn.jpg 500 × 459;145 KB
- Bk0nz.jpg 173 × 134;5 KB
- Gq0p6x27.jpg 253 × 268;11 KB
- Bk263.jpg 200 × 142;4 KB
- Gxpw7deo.jpg 213 × 246;13 KB
- Bk8n4.jpg 424 × 600;63 KB
- Glwc2euq.jpg 219 × 79;2 KB
- Bkpej.jpg 245 × 176;9 KB
- Bkbps.jpg 700 × 235;21 KB
- Gumvs3kt.jpg 390 × 555;15 KB
- Bkilc.jpg 162 × 141;7 KB
- Bk7p6.jpg 150 × 112;3 KB
- Bk51x.jpg 500 × 281;66 KB
- Gxq46t4c.jpg 345 × 378;17 KB
- Bk1p0.jpg 200 × 200;31 KB
- Gj6zp22m.jpg 366 × 291;12 KB
- Bkdeb.jpg 139 × 75;2 KB
- Bk5cx.jpg 443 × 540;50 KB
- Gum5qlwm.jpg 132 × 62;2 KB
- Bk4km.jpg 281 × 300;9 KB
- Guwgek7n.jpg 193 × 425;12 KB
- Bk92p.jpg 640 × 418;32 KB
- Bka7b.jpg 235 × 202;28 KB
- Bk10m.jpg 300 × 238;16 KB
- Tutu00007.jpg 845 × 565;78 KB
- Bkkog.jpg 139 × 136;6 KB
- Gxpqpeyc.jpg 554 × 318;18 KB